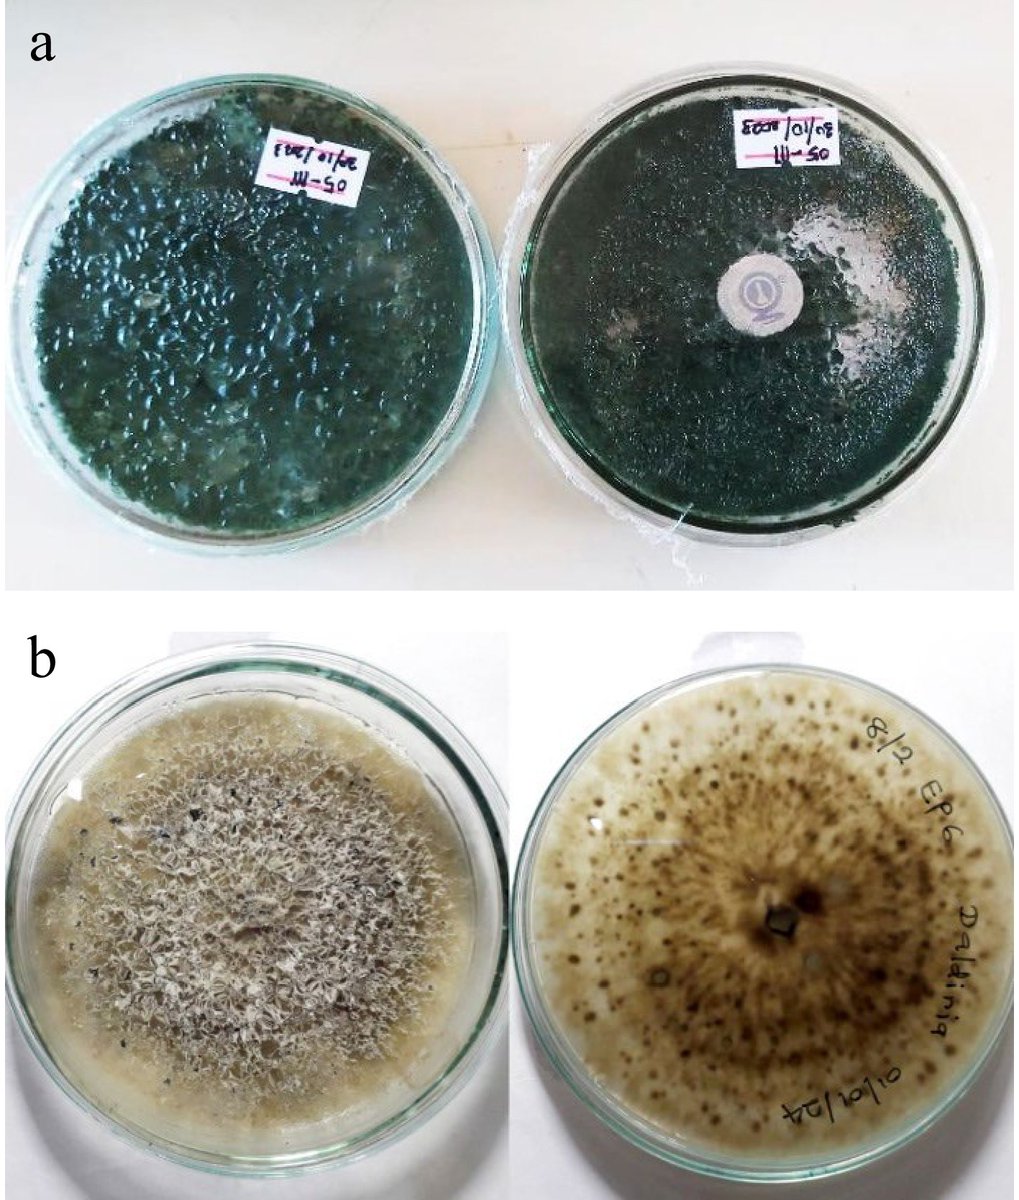
Ecological Agriculture Research tweet media

Sabitlenmiş Tweet

Circular Agricultural Systems is an open access, online-only journal, publishing top-tier original research articles, reviews, methods, editorials, and perspectives on optimizing #agricultural systems.
Learn more at maxapress.com/cas

English